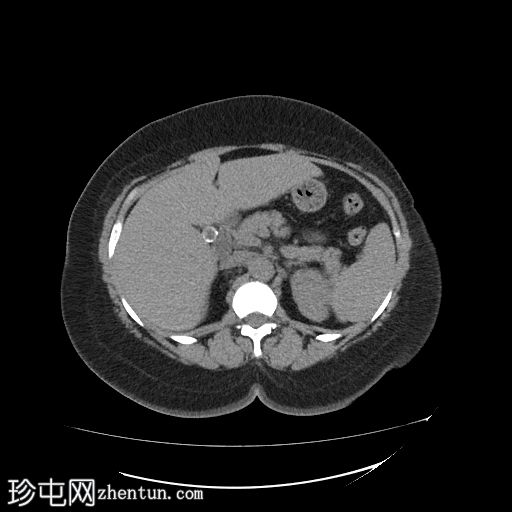
1.jpg

临床表现
腹痛,尤其在进食油腻食物后加剧。
患者资料
年龄:50岁
性别:女
CT
轴位
平扫
冠状位
平扫

矢状位
平扫

胆囊内可见多发大小不一的多面环状钙化胆结石。胆总管直径处于正常上限。胆总管内未见其他结石。
右侧肾中盏可见一非梗阻性结石(10.5 mm),CT值较高(900–1000 HU)。
病例讨论
钙化胆囊结石相对于胆汁呈高密度,因此是唯一能在CT图像上清晰显示的结石类型。在CT图像上,大部分胆固醇结石相对于胆汁呈低密度,而其他类型的胆结石与胆汁呈等密度,这些结石在CT图像上可能无法清晰显示。
右肾中盏可见高密度肾结石(900–1000 HU),提示为含钙硬结石,可能为草酸钙一水合物。 |